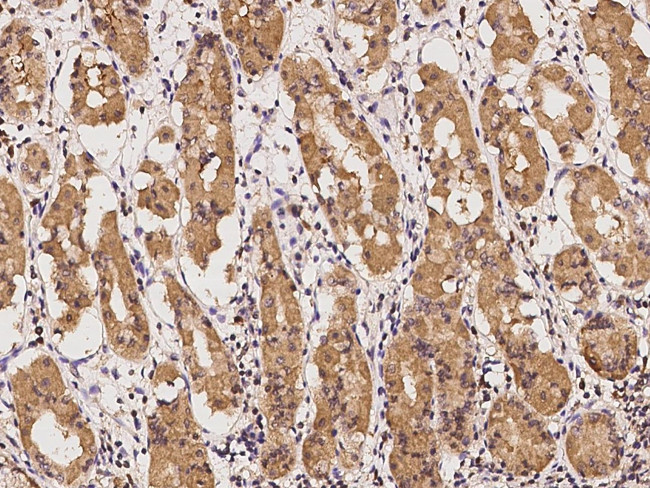
BOLA2 Antibody in Immunohistochemistry (Paraffin) (IHC (P))

Search
Invitrogen
BOLA2 Polyclonal Antibody
{{$productOrderCtrl.translations['antibody.pdp.commerceCard.promotion.promotions']}}
{{$productOrderCtrl.translations['antibody.pdp.commerceCard.promotion.viewpromo']}}
{{$productOrderCtrl.translations['antibody.pdp.commerceCard.promotion.promocode']}}: {{promo.promoCode}} {{promo.promoTitle}} {{promo.promoDescription}}. {{$productOrderCtrl.translations['antibody.pdp.commerceCard.promotion.learnmore']}}
产品信息
PA5-112308
宿主/亚型
分类
类型
抗原
偶联物
形式
保存条件
运输条件
RRID
靶标信息
This gene is located within a region of a segmental duplication on chromosome 16 and is identical to BOLA2B (bolA family member 2B). The product of this gene belongs to a family of proteins that are widely conserved and may be involved in iron maturation. Related pseudogenes are found multiple different chromosomes. Alternative splicing results in multiple transcript variants. Transcripts initiating at this locus may extend into downstream SMG1 pseudogene 6 (SMG1P6) and encode fusion proteins with a C-terminus related to SMG1 phosphatidylinositol 3-kinase-related kinase. A readthrough locus is represented with GeneID:107282092.
仅用于科研。不用于诊断过程。未经明确授权不得转售。